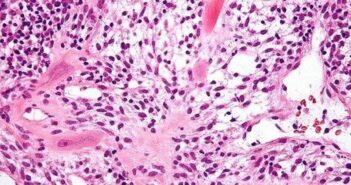

Debreceni kutatók tudományos áttörése a méhlepény sejtjeiről
A várandósság alatti folyamatok és szövődmények alaposabb megértéséhez, a jövőben pedig akár új terápiás lehetőségek…
A várandósság alatti folyamatok és szövődmények alaposabb megértéséhez, a jövőben pedig akár új terápiás lehetőségek…

Mintegy százezer ember él együtt epilepsziával Magyarországon, akiknek a tüneteken felül azzal is meg kell…

Gyermekmunka vagy csak játék a tartalomgyártó gyermekek tevékenysége? A Nemzeti Média- és Hírközlési Hatóság (NMHH)…
